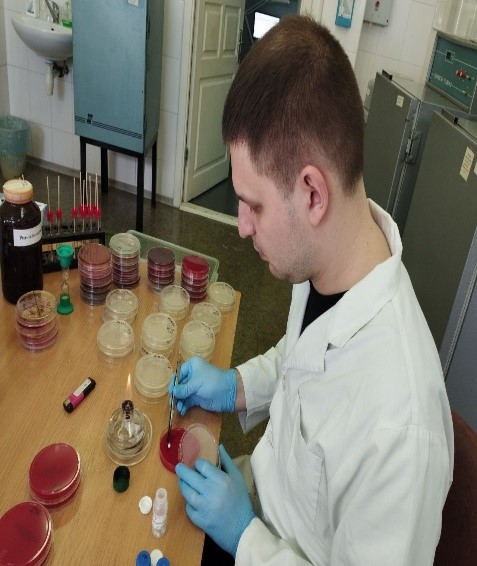

Лікар лікує людину, а ветеринар – людство!
Сьогодні відбулась розмова з нашим випускником Сергієм Бояновським – завідувачем сектору науково-аналітичного забезпечення реєстрації та експертизи досьє ветеринарних імунобіологічних засобів (ВІЗ) Державного науково-контрольного інституту біотехнології і штамів мікроорганізмів.

- Сергій, розкажіть про себе, ким працюєте?
Майже 7 років тому, у 2016 році отримав диплом лікаря ветеринарної медицини Національного університету біоресурсів і природокористування України. В тому ж році витримав конкурс і вступив до аспірантури НУБіП, під керівництвом професора Тетяни Мазур визначився з вектором наукового пошуку – напрямок моїх досліджень - вивчення особливостей прояву патогенного потенціалу у збудників бактеріальних хвороб тварин.
Майже три роки (2019-2021) працював на посаді молодшого наукового співробітника в Українській лабораторії якості та продукції АПК у науково-дослідному відділі мікробіологічних досліджень, де продовжив виконувати заплановані наукові дослідження.
Хочу відзначити, що в УЛЯБП АПК згідно до посадових обов’язків освоїв правила роботи в лабораторії згідно вимог міжнародного стандарту ISO 17025, оволодів низкою спеціальних методик: а саме – підготовки лабораторного посуду і приготування поживних різних середовищ для культивування мікроорганізмів; роботи з автоклавами; методи бактеріологічних досліджень продукції за кількісними мікробіологічними показниками якості і безпеки; методи оцінки якості мікробіологічних добрив і засобів захисту рослин за вмістом цільових бактерій; визначення чутливості різних видів бактерій до антибактеріальних засобів відповідно до міжнародних рекомендацій; методики ліофілізації мікроорганізмів, тощо.
З 2021 року працюю в Державному науково-контрольному інституті біотехнології і штамів мікроорганізмів, де займаю посаду завідувача сектору науково-аналітичного забезпечення реєстрації та експертизи досьє ветеринарних імунобіологічних засобів; являюсь вченим секретар секції ветеринарних імунобіологічних препаратів Державної фармакологічної комісії ветеринарної медицини.
Наразі готуюсь до захисту дисертаційної роботи, оформлюю результати наукових досліджень до публікації у вітчизняних та закордонних фахових виданнях, у т.ч. виданнях категорії Scopus.

- Що вплинуло на Вас у виборі професії і чи складно було обирати?
У виборі професії були певні складності, оскільки на час, коли я був абітурієнтом, я не був впевнений щодо своєї майбутньої професії. Але я точно знав, що хочу бачити себе в майбутньому вченим і мав жагу до знань біології.
З остаточним вибором професії мені допомогли мої рідні та вчителі, які, знаючи мої бажання та любов до всього живого, порадили мені професію лікаря ветеринарної медицини.

- Сергій Олександрович, професія лікаря ветеринарної медицини не з легких. Чи не шкодуєте?
Повинен вам з впевненістю сказати – не шкодую. Надзвичайно цікаво, є можливість для самореалізації, вдосконалення. Фах лікаря ветеринарної медицини відкриває перспективні і багатогранні можливості. І я маю плани ці можливості реалізувати - у поточному році планую захистити дисертаційну роботу та отримати звання доктора філософії зі спеціальності «Ветеринарна медицина».

- Розкажіть нам що цікавого запам’яталось за часи навчання. Які заняття та викладачі?
З дисциплін, які мені найбільш запам’ятались і викладачів то це, особисто для мене, цікавими були: анатомія (викладали професор Рудик С.К. та доцент Стегней М.М.), гістологія (доцент Мазуркевич Т.А.), фізіологія (доцент Кладницька Л.В.), мікробіологія (доцент Козловська Г.В.) та багато інших. Цікавою і інформативною була навчальна практика в навчально-дослідних господарствах де було отримано перші практичні навички.
- Як часто буваєте в стінах рідної факультету?
Доволі часто відвідую Національний університет біоресурсів і природокористування України, адже планую захист своєї дисертаційної роботи. Інколи зустрічаємось з одногрупниками і однокурсниками, з деякими співпрацюю в робочих питаннях. Необхідно відзначити, що Факультет постійно розвивається, вдосконалюється, оновлюється, що дуже приємно бачити коли потрапляєш сюди.
- Що можете порадити майбутнім абітурієнтам?
Бажаю вам успіху. Ще є час сконцентрувати знання отримані в школі і отримати високі бали необхідні для вступу на факультет ветеринарної медицини.
Вступайте на наш факультет, і ви отримаєте гідні знання і конкурентну професію, яка вимагає сміливості, кмітливості, глибоких знань.
Насамперед, треба мати мужність, щоб присвятити себе кращій на землі професії – бути лікарем ветеринарної медицини.
Розмову провів завідувач кафедри епізоотології, мікробіології і
вірусології, доцент Володимир Мельник